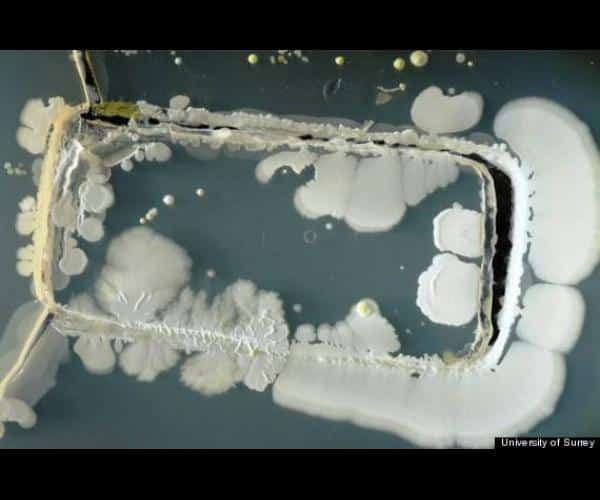

Le saviez-vous #361 : à quoi ressemblent les bactéries qui prolifèrent sur votre téléphone portable ?
On le sait, les téléphones portables contiennent 18 fois pus de bactéries que la cuvette des toilettes... Et oui ! toute la journée, vous faites trainer vos doigts qui traînent déjà partout, sur votre écran tactile en prenant bien soin d’étaler les bactéries d’un bout à l’autre ! Miam !
Après 3 jours dans un produit utilisé en bactériologie pour faire grandir les microbes plus vite, les scientifiques arrivent à ce joli résultat… Au programme salive (ça ok), nourriture, mais aussi sécrétions sexuelles ! De quoi aider ces jolies bactéries à bien se développer !
Bon rassurez-vous, dans la plupart des cas, ces bactéries sont inoffensives. Certaines peuvent tout de même causer quelques soucis de peau. Alors un petit conseil, n’hésitez pas à nettoyer votre smartphone aussi souvent que possible…
À lire aussi
Et bon appétit bien sûr !

Suite page 2
